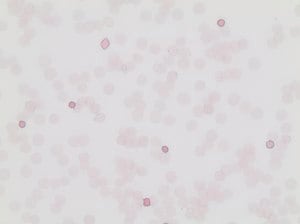
Fetal Hemoglobin Kit, 1 kit

2143 produits - Trié par pertinence

Réf. UGAP : 3613545 Réf. constructeur : SP-5030

Réf. UGAP : 3617543 Réf. constructeur : 15740-01

Réf. UGAP : 3721482 Réf. constructeur : ZD15

Réf. UGAP : 3737648 Réf. constructeur : D0550-25G

Réf. UGAP : 3721616 Réf. constructeur : K800421-2

Réf. UGAP : 3743551 Réf. constructeur : 285C-1KT

Réf. UGAP : 3656214 Réf. constructeur : 23004

Réf. UGAP : 3618385 Réf. constructeur : CLK-N002-10

Réf. UGAP : 3613311 Réf. constructeur : DL-1178

Réf. UGAP : 3617505 Réf. constructeur : 11652

Réf. UGAP : 3736938 Réf. constructeur : A3648-100ML

Réf. UGAP : 3657775 Réf. constructeur : 453278

Réf. UGAP : 3666890 Réf. constructeur : 3957701

Réf. UGAP : 3667079 Réf. constructeur : 2808502

Réf. UGAP : 3751392 Réf. constructeur : 198250-25G